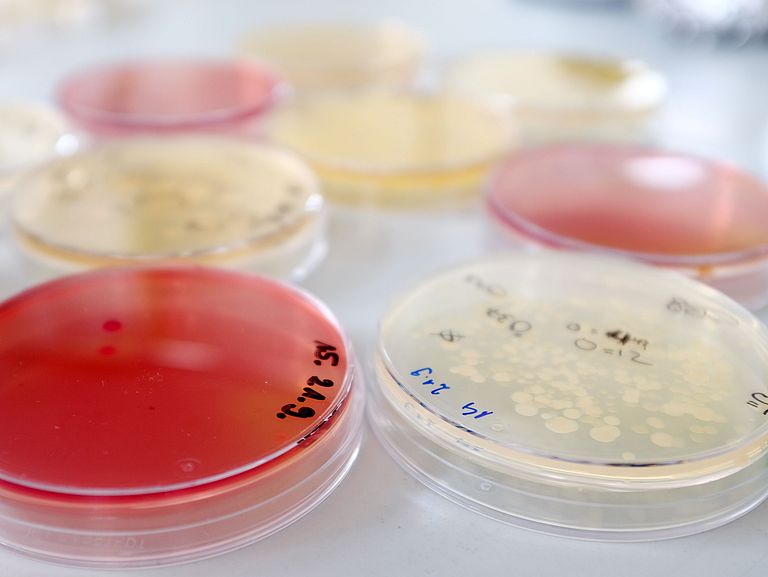

Leiterin der Forschungseinheit:
Prof. Dr. Deniz Tasdemir
GEOMAR Helmholtz-Zentrum für Ozeanforschung Kiel
Tel.: +49-431 600-4430
E-Mail: dtasdemir@geomar.de
Wischhofstraße 1 - 3
24148 Kiel
Assistenz/Geschäftszimmer:
Julia Chapela Collazo
Telefon: +49-431 600-4437
E-mail: jchapelacollazo@geomar.de